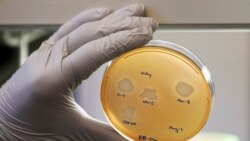
လည်ချောင်းနာခြင်း (အပိုင်း - ၁) လည်ချောင်းနာခြင်း (အပိုင်း - ၁)

လည်ချောင်းနာတာက ရာသီပြောင်းတာ၊ စားသောက်နေထိုင်တာတွေနဲ့ ဆက်စပ်နေပြီး၊၊ မြန်မာနိုင်ငံမှာ အဖြစ်များတယ်လို့ ကျန်းမာရေးပညာရှင်တွေက ဆိုကြပါတယ်။ လည်ချောင်းနာတာက အများအားဖြင့် ဗိုင်းရပ်စ် (virus) ပိုး ဝင်ရောက်တာကြောင့် ဖြစ်ပါတယ်။ ယေဘုယျအားဖြင့် ရာသီဥတုပြောင်းချိန် ဖြစ်လေ့ရှိတဲ့ တုပ်ကွေး (သို့မဟုတ်) ရိုးရိုးသာမန်ဖျားတာ ဖြစ်လာအပြီး၊ ကိုယ်လက်ကိုက်ခဲ နှာစေးကာ၊ လည်ချောင်းနာတာတွေ ဆက်ဖြစ်လာတတ်ပါတယ်။ အခုလို လည်ချောင်းနာတာ အဓိက ဖြစ်စေတာတွေကတော့ အာသီးရောင်တာ၊ အာခေါင်အနာဖြစ်တာ၊ အာခေါင် အာသီးနဲ့ လျှာအရင်း ကင်ဆာအကြိတ်ဖြစ်တာ၊ ကလေးတွေမှာ ဆုံဆို့နာ (Diphtheria) ဖြစ်တာ၊ အာခေါင်မှာ ထိခိုက်ရှနာဖြစ်တာနဲ့ အသံအိုးရောင်တာတွေကြောင့် ဖြစ်ပါတယ်။
တုပ်ကွေးနဲ့ အာသီးရောင်တာကို ကာကွယ်ဖို့အတွက် တုပ်ကွေးဖြစ်တတ်ချိန်တွေမှာ ကိုယ်ခံအားကောင်းနေဖို့ အိပ်တာ၊ စားတာ မှန်ဖို့လိုပါတယ်။ ကိုယ်ခံအားကောင်းနေခြင်းဖြင့် ဗိုင်းရပ်စ်ကြောင့် အာသီးရောင်တာ ဖြစ်လာလျှင်တောင် (၁) ရက် (၂) ရက်အတွင်း ပြန်ပျောက်သွားပြီး၊ နောက်ဆက်တွဲ ပိုဆိုးတဲ့ ဘက်တီးရီးယား (Bacteria) ပိုး မဝင်လာအောင် ကာကွယ်ပေးနိုင်ပါတယ်။ ဒါပေမဲ့ အာသီးထပ်ခါထပ်ခါရောင်ပြီး၊ အာသီးဘေးမှာ ပြည်တည်တာ များလာလျှင်တော့၊ အသက်ရူလမ်းကြောင်းကို ပိတ်စေနိုင်ကာ အသက်အန္တရာယ်ရှိနိုင်တာကြောင့် အာသီးကို ခွဲစိတ်ဖြတ်ထုတ်သင့်ပါတယ်။
အာခေါင်အနာဖြစ်တာကနေ ကာကွယ်ဖို့ကလည်း ကိုယ်ခံအားကျစေတဲ့ စိတ်ဖိစီးမူများတာ မဖြစ်ရအောင် ကာကွယ်နေထိုင်သင့်ပါတယ်။ အထူးသဖြင့် ခွဲစိတ်ပြီးကာစ လူနာတွေ၊ အိမ်နဲ့ဝေးပြီး ဆေးရုံတက်နေရသူတွေနဲ့ အလုပ်များသူတွေမှာ စိတ်ဖိစီးမူများပြီး ဒီ အာခေါင်အနာလေးတွေ ထွက်လာတတ်ပါတယ်။ အာခေါင်အနာကလည်း ဗိုင်းရပ်စ်ပိုးကြောင့် အဓိကဖြစ်ရပြီး၊ အကွက်လေးတွေ၊ အနီစက်လေးတွေ စထွက်လာကာ၊ နောက်ပိုင်း အဖြူကွက်အနာလေးတွေ အာခေါင်တဝိုက် ဖြစ်လာတတ်ပါတယ်။
ရေခဲရေနဲ့ ဓာတ်မတည့်သူတွေမှာ အာသီးရောင်တာ၊ အာခေါင်ရောင်တာ၊ အသံအိုးရောင်တာတွေ ပိုဖြစ်စေနိုင်ပါတယ်။ ဒါပေမဲ့ ရေခဲနဲ့ ဓာတ်တည့်သူတွေအတွက်တော့ ပြဿနာ မရှိပါဘူး။ ဒါပေမဲ့လည်း အာသီးရောင်တာကနေ ပြည်တည်တာ အဖြစ်များလာသူတွေမှာတော့ အချိုင့်လေးတွေကျန်ခဲ့ပြီး အစာတချို့ ကျန်နေတတ်ကာ၊ လည်ချောင်းနာတာ ပိုဖြစ်တတ်တာမို့၊ ရေခဲရေအပြင် တချို့မတည့်တဲ့အစာတွေ ဖြစ်နိုင်ရင် ဆီကြော်မုန့်၊ အချိုများတဲ့အစာ၊ မတည့်တဲ့ စားသုံးဆီ စတာတွေကို ရှောင်ကျဉ်သင့်ပါတယ်။
အာခေါင်၊ အာသီးနဲ့ လျှာရင်း ကင်ဆာအကြိတ်ဖြစ်တာကနေ ကာကွယ်ဖို့အတွက် ဆေးလိပ်သောက်တာ၊ အရက်အများကြီးသောက်တာနဲ့ ကွမ်းစားတာတွေကို ရှောင်ပြီး၊ ပါးစပ်ကို သန့်ရှင်းအာင် ထားပေးသင့်ပါတယ်။ ဒါ့အပြင် ကင်ဆာဖြစ်လာလျှင်လည်း စောစော ကြိုသိပြီး မပြင်းထန်သေးတဲ့ အဆင့် (အဆင့် တစ်၊ နှစ်) တွေမှာ အချိန်မီ ခွဲစိပ်ကုသပေးခြင်းဖြင့်လည်း ကင်ဆာဒဏ်ကို ကာကွယ်နိုင်ပါတယ်။ ကင်ဆာတချို့က အစပိုင်းမှာ လည်ချောင်းနာတာမဖြစ်စေပေမယ့် တချို့ အထူးသဖြင့် လျှာအရင်းကင်ဆာကတော့ အပြင်အထန်နာလေ့ ရှိပါတယ်။
ဒီရောဂါဆိုင်ရာအကြောင်း ပိုမိုသိရှိနားလည်နိုင်ဖို့ ကိုဝင်းမင်း က နား၊ နှာခေါင်း၊ လည်ချောင်း အထူးကု ဒေါက်တာသိန်းထွန်း ကို ဆက်သွယ်မေးမြန်းထားပါတယ်။